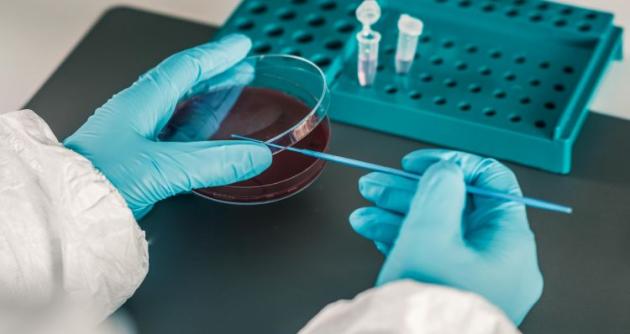

Chimbote en Línea. - El Instituto Nacional de Calidad (Inacal), organismo adscrito al Ministerio de la Producción, aprobó la Norma Técnica Peruana NTP-ISO 7101:2025 “Gestión de organizaciones para el cuidado de la salud. Sistemas de gestión de la calidad en las organizaciones para el cuidado de la salud. Requisitos”, la cual establece lineamientos para que hospitales, clínicas, centros médicos y otras entidades del sector implementen sistemas de gestión de calidad orientados a brindar una atención de salud más segura, efectiva, equitativa y centrada en las personas.
Esta norma técnica recoge las mejores prácticas reconocidas a nivel global y responde a los principales desafíos de los sistemas de salud: el incremento de enfermedades crónicas, el envejecimiento de la población, la escasez de recursos, la incorporación de nuevas tecnologías y las crecientes exigencias de calidad tras la pandemia.
Puede ser implementada por organizaciones de todo tipo y tamaño, como ministerios de salud, hospitales públicos y privados, clínicas, laboratorios, ONGs, servicios de telemedicina y entidades que brindan cuidados domiciliarios.
La implementación de la NTP-ISO 7101:2025 representa un avance estratégico para fortalecer el sistema de salud peruano, ya que proporciona una herramienta que permitirá mejorar la experiencia del paciente, elevar la seguridad y garantizar una atención continua en la prestación de servicios médicos.
Según la Organización Mundial de la Salud, 1 de cada 10 pacientes hospitalizados sufre daños evitables durante la atención. En ese contexto, la adopción de normas de gestión de calidad busca precisamente reducir estos riesgos mediante la estandarización de procesos y el monitoreo de la calidad asistencial.
DIFUSIÓN EN LOS JUEVES DE NORMALIZACIÓN
Con el objetivo de promover su adopción, el Inacal, a través de la Dirección de Normalización, presentará la NTP-ISO 7101:2025 en el marco de los “Jueves de Normalización”, el próximo 18 de setiembre a las 15:00 horas en modalidad virtual (plataforma Zoom).
El evento contará con la participación de expertos del Comité Técnico de Normalización de Pruebas de Laboratorio Clínico y Diagnóstico In Vitro, quienes explicarán los beneficios de la norma y atenderán consultas de los asistentes. La participación es gratuita y está dirigida a profesionales del sector salud, representantes de instituciones públicas y privadas, así como a la ciudadanía interesada.
La calidad en la atención es un factor clave para alcanzar la Cobertura Universal de Salud, compromiso asumido por el país ante la Organización Mundial de la Salud, y la NTP-ISO 7101:2025 constituye una herramienta concreta para avanzar hacia este objetivo.
Para participar en el evento gratuito se requiere inscripción previa en el siguiente enlace: https://servicios.inacal.gob.pe/registro/inicio.php?codigo=DN2025JN09
Comentarios
Comentar